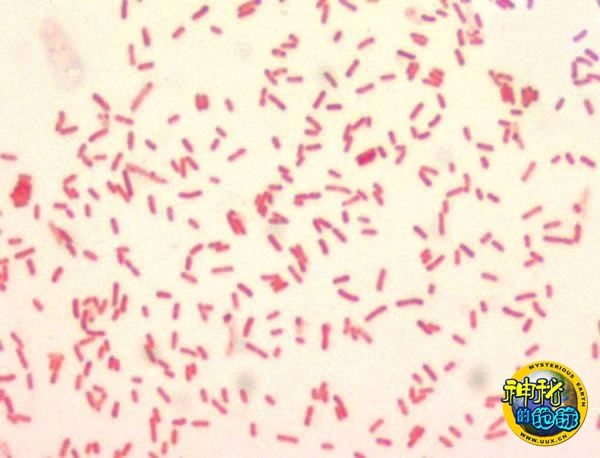

瘟疫病原体起源于中国或其附近
黑死病的致病细菌Yersinia pestis
黑死病的致病细菌Yersinia pestis
一个国际科学家团队正在利用DNA指纹分析技术,追本溯源的调查最近10000年内发生的全球性典型瘟疫疾病传播事件,他们关于瘟疫病原体鼠疫桿菌(Yersinia pestis)的研究结果即将刊登于《自然遗传学》杂志上。
DNA指纹分析技术是指将个体的染色体DNA用限制性内切酶消化,分离得到不同大小的DNA片段,再以重复序列中的共有序列作为核酸探针进行杂交,对所得到不同生物个体相似DNA片段的带型图谱进行分析的方法。能揭示并比较生物个体间关系的密切程度,有效地应用于遗传分析、法医和亲子鉴定等。
Keim 解释说:“我们主要进行的工作是建立一个控制沙门氏菌、大肠杆菌和流行性感冒的模型。”历史上的瘟疫利用人类在全球范围内的密切往来而广泛传播,就类似现今的流感和食源性疾病。未来的流行病学家可以通过对毁灭性疾病的传播史进行千年尺度上的恢复,来预防和控制传染病爆发。
跟踪瘟疫的全球性传播路径需要尽可能多的识别菌株的变异,但由于在国际间转移活细菌因其可能的危险性一般被高度限制,这对科学家们提出了挑战。
为了使研究成行,科研小组想出来一个创新性的研究策略,分散在全球各地的实验室分摊整个工程,每家仅仅负责17种瘟疫基因序列中的若干。小组整合所有数据,确认DNA序列上存在几百个突变点。最后绘制出一张瘟疫如何在全球传播的地图。
他们的合作研究发现,瘟疫病原体起源于中国或其附近,形成发展并导致多次全球大流行。研究团队也确认了瘟疫的变异具有国别性的差异。
瘟疫传播其实是沿着人类商业活动的贸易路线,最早可以追溯到公元15世纪。中国探险家郑和的航线可能将瘟疫带到了中非国家。马可波罗书中描述过的丝绸之路,一路从中国延伸到西亚和欧洲,也为瘟疫传播提供了通道。最新的瘟疫大流行发生在19世纪末期,今天依然在美国西部的野生啮齿动物中肆虐。
助理教授Wagner说:“黑死病在19世纪末和20世纪初波及美国,主要由船上被感染的老鼠携带到港口城市,进而进入内地。基于DNA比较,我们确定,感染美国的瘟疫病毒株起源于亚洲,并且很有可能是通过夏威夷群岛到达加利福尼亚州的。”
尽管瘟疫流行已成为了过去,但疾病从没完全消失过。放眼世界,病菌已经在全球动物种群中扎根,而且在非洲和马达加斯加岛大有抬头之势。 世界卫生组织官员E.Carniel说:“我们应该思考的并不只是疾病过去的历史,而要提防它们的悄然抬头之势,此刻的安静很可能是假象。因此,只要病菌没灭绝,我们就不能放松警惕。”
来源:化石网/dz